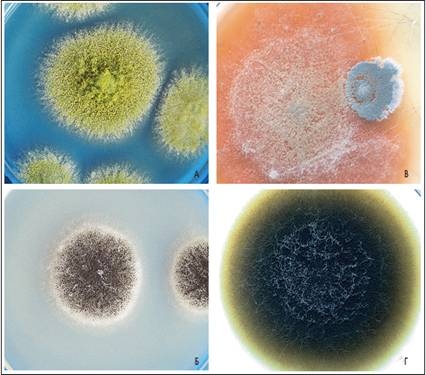

Грибы рода Trichoderma: коллекция фотографий

Раздел: Мир вокруг нас